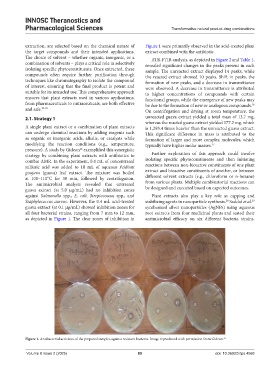

Page 95 - ITPS-8-2
P. 95
INNOSC Theranostics and
Pharmacological Sciences Transformative natural product-drug combinations
extraction, are selected based on the chemical nature of Figure 1 were primarily observed in the acid-treated plant
the target compounds and their intended applications. extract combined with the antibiotic.
The choice of solvent – whether organic, inorganic, or a ATR-FTIR analysis, as depicted in Figure 2 and Table 1,
combination of solvents – plays a critical role in selectively revealed significant changes in the peaks present in each
isolating specific phytoconstituents. Once extracted, these sample. The unreacted extract displayed 14 peaks, while
compounds often require further purification through the reacted extract showed 10 peaks. Shift in peaks, the
techniques like chromatography to isolate the compound formation of new peaks, and a decrease in transmittance
of interest, ensuring that the final product is potent and were observed. A decrease in transmittance is attributed
suitable for its intended use. This comprehensive approach to higher concentrations of compounds with certain
ensures that plant extracts used in various applications, functional groups, while the emergence of new peaks may
from pharmaceuticals to nutraceuticals, are both effective be due to the formation of new or analogous compounds.
26
and safe. 23-25 On centrifugation and drying at room temperature, the
2.1. Strategy 1 unreacted guava extract yielded a total mass of 13.7 mg,
whereas the reacted guava extract yielded 177.2 mg, which
A single plant extract or a combination of plant extracts is 1,293.4 times heavier than the unreacted guava extract.
can undergo chemical reactions by adding reagents such This significant difference in mass is attributed to the
as organic or inorganic acids, alkalis, or catalysts while formation of larger and more complex molecules, which
modifying the reaction conditions (e.g., temperature, typically have higher molar masses. 27
26
pressure). A study by Gideon exemplified this synergistic
strategy by combining plant extracts with antibiotics to Further exploration of this approach could involve
combat AMR. In the experiment, 0.4 mL of concentrated isolating specific phytoconstituents and then initiating
sulfuric acid was added to 10 mL of aqueous Psidium reactions between non-bioactive constituents of one plant
guajava (guava) leaf extract. The mixture was boiled extract and bioactive constituents of another, or between
at 100–110°C for 30 min, followed by centrifugation. different solvent extracts (e.g., chloroform or n-hexane)
The antimicrobial analysis revealed that untreated from various plants. Multiple combinatorial reactions can
guava extract (at 5.0 μg/mL) had no inhibition zones be designed and executed based on expected outcomes.
against Salmonella spp., E. coli, Streptococcus spp., and Plant extracts also play a key role as capping and
Staphylococcus aureus. However, the 0.4 mL acid-treated stabilizing agents in nanoparticle synthesis. Saddaf et al.
28
29
guava extract (at 0.1 μg/mL) showed inhibition zones for synthesized silver nanoparticles (AgNPs) using aqueous
all four bacterial strains, ranging from 7 mm to 12 mm, root extracts from four medicinal plants and tested their
as depicted in Figure 1. The clear zones of inhibition in antimicrobial efficacy on six different bacteria strains.
Figure 1. Antibacterial activities of the prepared samples against resistant bacteria. Image reproduced with permission from Gideon. 26
Volume 8 Issue 2 (2025) 89 doi: 10.36922/itps.4068